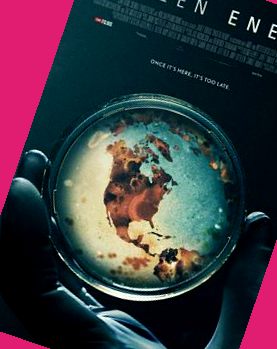

正在觀看《日韩av电子书,少妇被粗黑进进出出在线观看》全集
相關推薦
猜你喜歡
- 70418次觀看
- 64879次觀看
- 79060次觀看
- 91370次觀看
- 94369次觀看
- 65612次觀看
- 39014次觀看
- 21449次觀看
- 72977次觀看
- 13813次觀看
- 5399次觀看
- 22371次觀看
- 14759次觀看
- 40352次觀看
- 82123次觀看
- 10363次觀看
- 33331次觀看
- 30520次觀看
- 47614次觀看
- 22902次觀看
- 45007次觀看
- 21755次觀看
- 47247次觀看
- 36703次觀看
- 23843次觀看
- 4237次觀看
- 47109次觀看
- 38224次觀看
- 42451次觀看
- 61140次觀看
- 66199次觀看
- 20384次觀看
- 68931次觀看
- 68546次觀看
- 66589次觀看
- 543次觀看
- 30951次觀看
- 76940次觀看
- 17576次觀看
- 65205次觀看
- 57975次觀看
- 97973次觀看
- 71442次觀看
- 92622次觀看
- 59556次觀看
- 44319次觀看
- 93043次觀看
- 9815次觀看
- 65312次觀看
- 36882次觀看
- 95000次觀看
- 21725次觀看
- 11332次觀看
- 28083次觀看
- 62167次觀看
- 3610次觀看
- 41096次觀看
- 20812次觀看
- 3560次觀看
- 78977次觀看